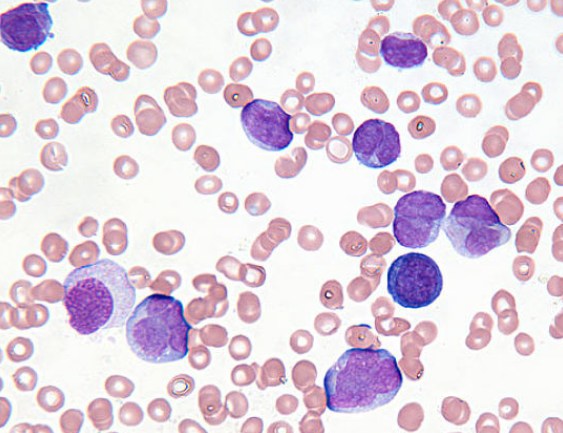

【资讯导读】博舒替尼是另一种TKI靶向BCRABL蛋白。它可以作为慢性粒细胞白血病的第一种治疗方法,但通常在另一种TKI疗法不起作用时使用。每天服一次药丸。 博舒替尼的副作用:常见的
博舒替尼是另一种TKI靶向BCRABL蛋白。它可以作为慢性粒细胞白血病的第一种治疗方法,但通常在另一种TKI疗法不起作用时使用。每天服一次药丸。
博舒替尼的副作用:常见的副作用通常是轻微的,包括腹泻、恶心、呕吐、腹部疼痛、皮疹、发热、疲劳和低血细胞计数(包括低血小板计数、低红细胞计数和低白细胞计数)。不太常见的是,这种药物还会导致液体潴留、肝损伤和严重的过敏反应。你的医生会定期检查你的血液测试结果,以观察你的肝脏问题和低血计数。
普纳替尼是一种新的第三代TKI靶向BCR-ABL蛋白。因为这种药物可能会引起一些严重的副作用,如果其他所有TKI都不起作用或者他们的白血病细胞有一种叫做T315I突变的基因变化,它只用于治疗慢粒患者。帕那替尼是第一个用这种突变来抵抗慢性粒细胞白血病细胞的TKI人。是一天服一次的药丸,不管有没有入食。
普纳替尼的副作用:大多数副作用是轻微的,可能包括腹部疼痛、头痛、皮疹或其他皮肤问题以及疲劳。高血压也很常见,可能需要服用降压药。
还存在严重血栓形成的风险,这可能导致心脏病发作和中风,或者阻塞手臂和腿部的动脉和静脉。很少情况下,服用这种药物的患者体内的血凝块会切断血液循环,导致手臂或腿部截肢。可能需要手术或其他程序来治疗这些血凝块。老年患者患严重血栓形成的风险更高。有某些危险因素的人,如高血压、高胆固醇或糖尿病;那些患有心脏病、中风或血液循环不良的人。
不太常见的是,这种药物还会削弱心肌,导致一种叫做充血性心力衰竭的疾病。它还会导致肝脏问题,包括肝功能衰竭和胰腺炎(胰腺炎症,可导致严重的腹痛、恶心和呕吐)。
普纳替尼药品详细信息请进入:https://www.inmedf.com/zhongliu/bxb/20201810.html